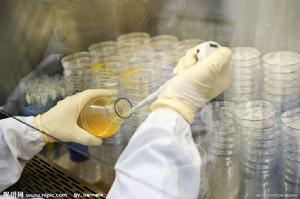
化學分析

法定的第三方
浙江產品質量監督檢驗研究院成立於1983年9月,又名國家技術監督局浙江電氣安全檢驗所、浙江省試驗
 檢測大樓
檢測大樓浙江質檢院是國家質量監督檢驗檢疫總局和浙江省質量技術監督局屬下的法定第三方專門從事產品質量檢驗和認證的機構、中國合格評定國家認可委員會認可的國家級實驗室和檢查機構、國際電工委員會電工設備及元件合格評定體系組織認可的國際CB實驗室、中國國家認證認可監督管理委員會指定的國家強制性產品認證檢測機構,也是中國質量認證中心等國家級認證機構簽約的實驗室。
浙江質檢院現有1個總部,2個基地,擁有現代化實驗室和辦公場所6萬平方米,固定資產超5億元,各類高素質的專業技術和管理人員680多名,先進的檢測、校準儀器設備逾8000台(套),已取得2650多個產品及項目的檢測、檢查及校準的國際和國家資質,涉及標準7360多個,是集檢測、校準、認證、標準制修訂與研究於一體,具備國際先進、國內領先水平的專業與權威的認證檢測機構。
技術實力
浙江質檢院的檢測實驗室和檢查機構滿足國際標準ISO/IEC 17025和ISO/IEC 17020的要求,獲中國合格評定國家認可委員會實驗室CNAS認可、國家認監委和浙江省質量技術監督局的CAL和CMA資質認定,出具的檢驗報告獲得國際實驗室認可合作組織多邊互認協定(ILAC-MRA)的50多個成員互認。
 技術研討
技術研討浙江質檢院從20世紀80年代起,先後代理了德國VDE、義大利IMQ、法國LCIE、英國BSI、荷蘭KEMA、挪威NEMKO、瑞士SEV、南非SABS、巴西UCIEE和IFBQ等多家國外著名認證機構在華的工廠檢查和產品檢測工作,並協助眾多中國企業獲取國外產品認證和質量管理體系認證,為我國產品出口作出了貢獻。
浙江質檢院屬下的浙江質檢中誠認證有限公司(CTC),是具有獨立法人資格的第三方認證權威機構(批准號:CNCA-R-2002-049)。業務範圍包括體系認證和產品認證,體系認證的領域為ISO9001、ISO14001和OHSMS18001等;產品認證範圍包括家具、玩具、化學化工、塑膠製品、電子電器等近20大類產品,認證的類型分為合格認證、安全認證、環保認證、節能認證等。 2006年3月,浙江質檢院順德基地落成啟用。順德基地檢測業務覆蓋家具、食品、塗料、化工、機械、電器、珠寶等19大類1270多個項目,是我國目前規模最大、資質最全的現代化、集約化檢測與認證基地之一。
2007年5月,浙江質檢院杭州基地落成啟用。設在杭州基地的國家中低壓輸配電設備質量監督檢驗中心為A級國家質檢中心,短路試驗能力達到了450V、280kA,是目前全國同類實驗室中短路試驗能力最大的,也是東南亞地區唯一具備變壓器突發短路試驗能力的實驗室。
檢測技術服務
浙江質檢院的業務範圍主要包括電氣、電子、信息技術、電磁兼容(EMC)、機械、塑膠、家具、食品
化學分析
化學分析聯繫方式
杭州天目山路222號二號樓
